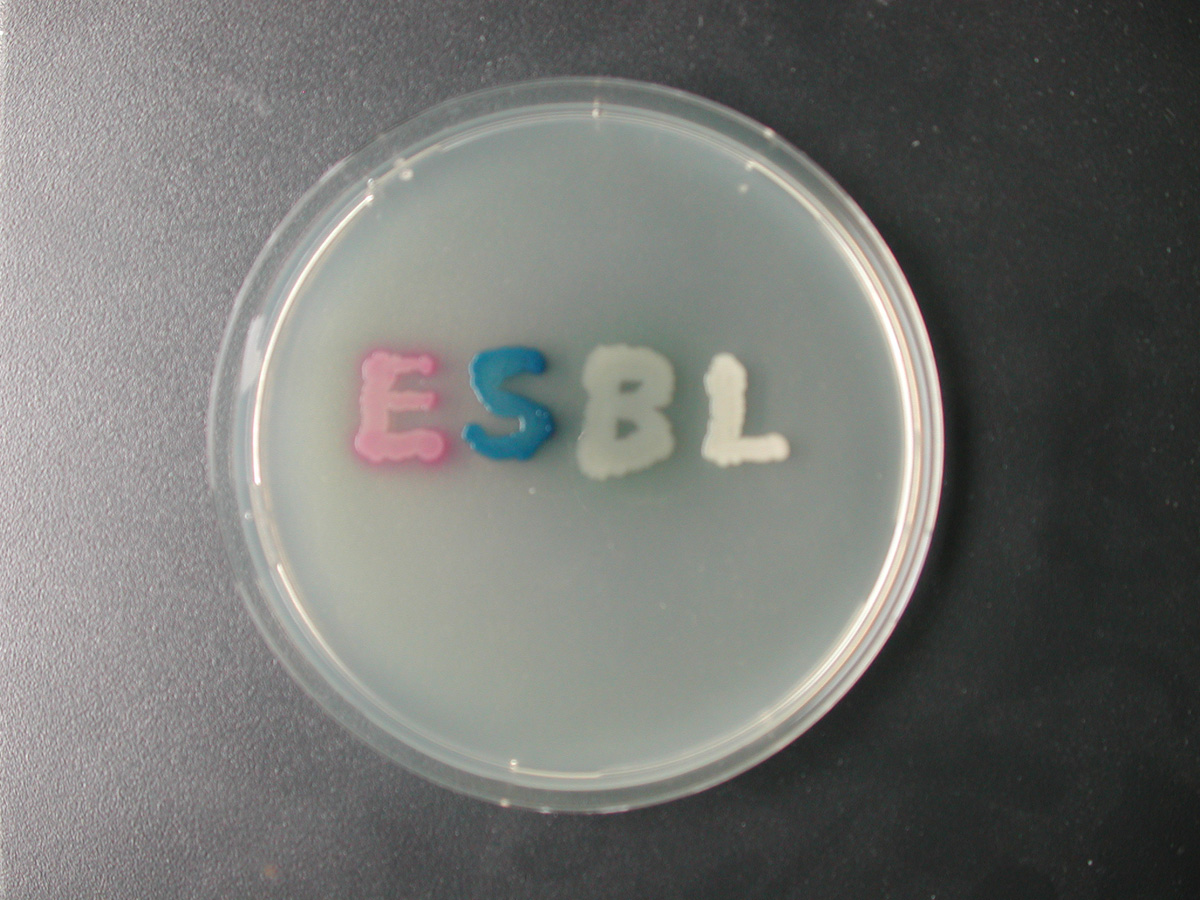

À propos du produit
Milieu chromogène pour la détection des bactéries Gram-négatives productrices de BétaLactamases à Spectre Entendu.

Milieu chromogène pour la détection des bactéries Gram-négatives productrices de BétaLactamases à Spectre Entendu.